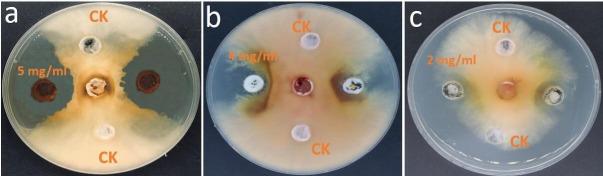
https://cdn.ncbi.nlm.nih.gov/pmc/blobs/ebe3/10986469/3e4e06bc2d14/spectrum.04008-23.f003.jpg
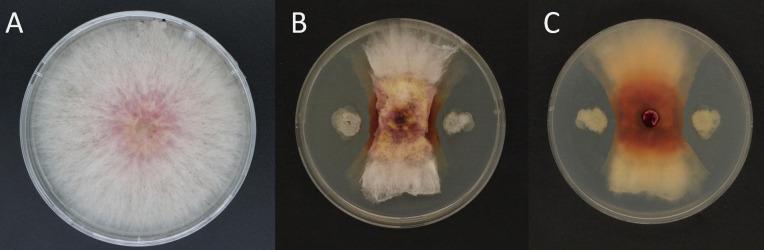
https://cdn.ncbi.nlm.nih.gov/pmc/blobs/ebe3/10986469/dedab27e53b9/spectrum.04008-23.f001.jpg

Sh420 菌株所产脂肽的抗真菌潜力对抗 ……
Antifungal potential of lipopeptides produced by the Sh420 strain against .
机构信息
Key Laboratory of Agro-products Quality and Safety Control in Storage and Transport Process, Ministry of Agriculture and Rural Affairs/Institute of Food Science and Technology, Chinese Academy of Agricultural Sciences, Beijing, China.
College of Agricultural Engineering and Food Science, Shandong University of Technology, Zibo, Shandong, China.
出版信息
Microbiol Spectr. 2024 Apr 2;12(4):e0400823. doi: 10.1128/spectrum.04008-23. Epub 2024 Mar 7.
Biological control is a more sustainable and environmentally friendly alternative to chemical fungicides for controlling spp. infestations. In this work, Sh420 isolated from wheat rhizosphere showed a high antifungal activity against as a secure substitute for fungicides. Sh420 was identified as using phenotypic evaluation and 16S rDNA gene sequence analysis. An antagonistic study showed that Sh420's lipopeptide (LP) extract exhibited strong antifungal properties and effectively combated . Meanwhile, lipopeptides have the ability to decrease ergosterol content, which has an impact on the overall structure and stability of the plasma membrane. The PCR-based screening revealed the presence of antifungal LP biosynthetic genes in this strain's genomic DNA. In the crude LP extract of Sh420, we were able to discover several LPs such as bacillomycin, iturins, fengycin, and surfactins using ultra-high-performance liquid chromatography-quadrupole time-of-flight mass spectrometry. Microscopic investigations (fluorescent/transmission electron microscopy) revealed deformities and alterations in the morphology of the phytopathogen upon interaction with LPs. Sh420 LPs have been shown in grape tests to be effective against infection and to stimulate antioxidant activity in fruits by avoiding rust and gray lesions. The overall findings of this study highlight the potential of Sh420 lipopeptides as an effective biological control agent against infestations.IMPORTANCEThis study addresses the potential of lipopeptide (LP) extracts obtained from the strain identified as Sh420. This Sh420 isolate acts as a crucial player in providing a sustainable and environmentally friendly alternative to chemical fungicides for suppressing phytopathogen. Moreover, these LPs can reduce ergosterol content in the phytopathogen influencing the overall structure and stability of its plasma membrane. PCR screening provided confirmation regarding the existence of genes responsible for biosynthesizing antifungal LPs in the genomic DNA of Sh420. Several antibiotic lipopeptide compounds were identified from this bacterial crude extract using ultra-high-performance liquid chromatography-quadrupole time-of-flight mass spectrometry. Microscopic investigations revealed deformities and alterations in the morphology of upon interaction with LPs. Furthermore, studies on fruit demonstrated the efficacy of Sh420 LPs in mitigating infection and stimulating antioxidant activity in fruits, preventing rust and gray lesions.
生物防治是一种比化学杀菌剂更可持续和环保的替代方法,可用于控制 spp. 感染。在这项工作中,从小麦根际中分离出的 Sh420 对 表现出很高的抗真菌活性,可作为杀菌剂的安全替代品。Sh420 通过表型评估和 16S rDNA 基因序列分析被鉴定为 。拮抗研究表明,Sh420 的脂肽(LP)提取物具有很强的抗真菌特性,能有效防治 。同时,脂肽能够降低麦角固醇含量,从而影响质膜的整体结构和稳定性。基于 PCR 的筛选显示,该菌株的基因组 DNA 中存在抗真菌 LP 生物合成基因。在 Sh420 的粗 LP 提取物中,我们能够使用超高效液相色谱-四极杆飞行时间质谱法发现几种 LP,如杆菌霉素、iturins、fengycins 和 surfactins。显微镜研究(荧光/透射电子显微镜)显示,LP 与植物病原菌相互作用后,其形态发生变形和改变。在葡萄试验中,Sh420 LP 被证明能有效防治 感染,并通过避免锈病和灰斑来刺激果实中的抗氧化活性。本研究的总体结果强调了 Sh420 脂肽作为防治 侵染的有效生物防治剂的潜力。
重要性
本研究关注从鉴定为 Sh420 的菌株中获得的脂肽(LP)提取物的潜力。这种 Sh420 分离株是一种重要的参与者,为抑制 植物病原菌提供了一种可持续和环保的替代化学杀菌剂的方法。此外,这些 LP 可以降低植物病原菌中的麦角固醇含量,影响其质膜的整体结构和稳定性。PCR 筛选证实 Sh420 基因组 DNA 中存在负责合成抗真菌 LP 的基因。使用超高效液相色谱-四极杆飞行时间质谱法从这种细菌粗提物中鉴定出几种抗生素脂肽化合物。显微镜研究显示,LP 与 相互作用后,其形态发生变形和改变。此外,在果实研究中,Sh420 LP 被证明能有效减轻 感染并刺激果实中的抗氧化活性,防止锈病和灰斑。